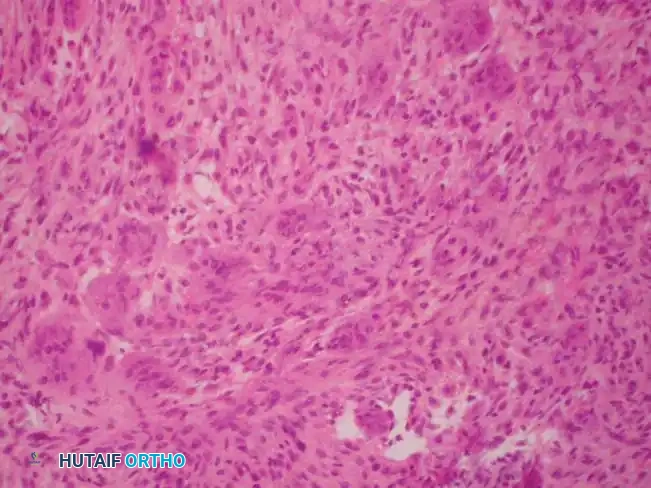
Image

INTRODUCTION TO BENIGN AND NONNEOPLASTIC BONE LESIONS
The diagnosis and management of benign, nonneoplastic, and metabolic bone lesions require a rigorous, multidisciplinary approach. While many of these lesions are discovered incidentally and follow a benign clinical course, they can occasionally present with aggressive features, impending pathological fractures, or severe pain. The orthopedic surgeon must possess a profound understanding of the radiographic, histological, and biomechanical characteristics of these entities to differentiate them from malignant sarcomas and to execute precise surgical interventions when indicated.
FATTY TUMORS OF BONE
Intraosseous Lipoma
Intraosseous lipoma is a relatively rare benign lesion of the skeletal system, standing in stark contrast to the ubiquitous nature of its soft-tissue counterpart. The true epidemiological incidence remains elusive, primarily because the vast majority of these lesions are entirely asymptomatic and never prompt medical evaluation. They are most frequently discovered as incidental findings on radiographs obtained for unrelated reasons.
Pathophysiology and Imaging
Intraosseous lipomas undergo a well-documented evolutionary process, often categorized by the Milgram classification. Early-stage lesions consist of viable adipose tissue, while later stages exhibit central necrosis, cyst formation, and dystrophic calcification due to localized ischemia.
Radiographically, the appearance varies depending on the stage but generally maintains benign characteristics. They typically present as well-defined, geographic lucencies, often bordered by a thin, sclerotic rim of reactive bone.



Fig. 20-19: (A) Intraosseous lipoma in the left proximal femur of a 51-year-old man. (B and C) The lesion demonstrates the same signal characteristics as normal macroscopic fat on both T1- and T2-weighted MRI sequences.
Advanced imaging is highly specific. Computed Tomography (CT) and Magnetic Resonance Imaging (MRI) reveal well-defined lesions exhibiting the exact signal characteristics of macroscopic fat (hyperintense on T1, suppressing on fat-saturated sequences). Central necrosis or targetoid calcification is frequently evident, representing infarcted adipose tissue. Because imaging is usually pathognomonic, a diagnostic biopsy is rarely necessary.
Surgical Management
Surgery is strictly reserved for the rare symptomatic lesion or when the structural integrity of the bone is compromised, leading to an impending pathological fracture.
- Positioning and Approach: The patient is positioned based on the anatomic location (most commonly the calcaneus, proximal femur, or tibia). A direct surgical approach is utilized to expose the affected cortex.
- Cortical Window: A rectangular or oval cortical window is created using a high-speed burr or osteotomes. The window must be large enough to allow complete visualization of the cavity.
- Intralesional Curettage: Thorough intralesional curettage is performed. The contents typically consist of yellow, fatty material intermixed with necrotic debris.
- Adjuvant Treatment: While extended curettage with high-speed burring is standard, chemical adjuvants (like phenol) are generally unnecessary for lipomas.
- Bone Grafting: The resulting cavitary defect is packed with cancellous autograft, allograft chips, or demineralized bone matrix (DBM) to restore biomechanical integrity.
Clinical Pearl: Always evaluate the structural integrity of the weight-bearing axis. If the intraosseous lipoma occupies more than 50% of the cortical diameter in a long bone, prophylactic internal fixation should be considered in conjunction with curettage and grafting.
Differential Diagnosis: Cystic and Ganglionic Lesions
When evaluating lucent bone lesions, the differential diagnosis must include Aneurysmal Bone Cysts (ABCs) and Intraosseous Ganglions.

Fig. 20-16: (A) Aneurysmal bone cyst of the right proximal humerus presenting with a pathological fracture in a 14-year-old girl. (B) Histological appearance showing blood-filled spaces lacking endothelial lining. (C) Radiographic appearance one year after extended curettage and grafting with cancellous bone chips and demineralized bone matrix.



Fig. 20-17: (A) Recurrent aneurysmal bone cyst of the left superior pubic ramus in a 14-year-old boy. (B) Axial MRI demonstrating the classic multiple fluid-fluid levels. (C) Two years post-resection, demonstrating excellent incorporation and no evidence of recurrence.


Fig. 20-18: (A and B) Plain radiograph and coronal MRI demonstrating an intraosseous ganglion in the right proximal humerus of a 31-year-old woman, a critical differential for benign epiphyseal/metaphyseal lucencies.
VASCULAR TUMORS
Hemangioma of Bone
Hemangioma is a remarkably common benign vascular lesion of bone. Epidemiological studies estimate that up to 10% of the general population harbors asymptomatic hemangiomas within the vertebral bodies. They are also frequently encountered in the calvarium. Conversely, hemangiomas arising in the appendicular skeleton (long bones of the extremities) are relatively uncommon.
Clinical Presentation and Imaging
Most hemangiomas are discovered incidentally. Spinal lesions are rarely symptomatic unless they exhibit aggressive features, such as vertebral body collapse, or extraosseous soft-tissue extension resulting in nerve root or spinal cord compression.

Fig. 20-20: Lateral radiograph of the lumbar spine demonstrating the typical “jailhouse” appearance of a vertebral hemangioma, characterized by prominent vertical trabecular striations.
The radiographic signature in the spine is highly characteristic. Resorption of horizontal trabeculae combined with compensatory thickening of vertically oriented trabeculae produces the classic "jailhouse" or "corduroy cloth" appearance. On axial CT imaging, these thickened trabeculae manifest as a distinct "polka dot" pattern. MRI is definitive; the lesions are typically hyperintense on both T1- and T2-weighted images due to the presence of intralesional fat and slow-flowing blood.
Biopsy is rarely required. When performed, histological analysis reveals a proliferation of normal-appearing, thin-walled capillary or cavernous blood vessels interspersed with adipose tissue.
Surgical Management and Embolization
Treatment is entirely unnecessary for asymptomatic lesions. However, multiple therapeutic avenues exist for symptomatic cases:
- Spinal Lesions: Neurological compromise secondary to vertebral collapse or epidural extension necessitates urgent nerve root or spinal cord decompression coupled with rigid spinal stabilization.
- Appendicular Lesions: Symptomatic lesions in long bones are adequately treated with extended intralesional curettage.
- Preoperative Embolization: This is a critical, non-negotiable step for large or spinal hemangiomas. Preoperative selective arterial embolization (using polyvinyl alcohol particles or coils) performed 24 to 48 hours prior to surgery drastically minimizes intraoperative blood loss, which could otherwise be catastrophic.
- Alternative Therapies: Selective arterial embolization can serve as definitive monotherapy for symptomatic lesions in surgically inaccessible locations. Low-dose radiation therapy remains an option for inoperable lesions but carries a documented, albeit low, risk of secondary malignant degeneration (radiation-induced sarcoma).
Surgical Warning: Never attempt open curettage of a large bone hemangioma without prior angiography and embolization. The intraosseous vascular channels lack contractile elements, leading to massive, uncontrollable hemorrhage upon breaching the cortex.
OTHER NONNEOPLASTIC LESIONS
Paget Disease of Bone (Osteitis Deformans)
Paget disease is a chronic, focal disorder of unregulated and chaotic bone remodeling. While the exact etiology remains uncertain, the discovery of paramyxovirus-like inclusion bodies within the nuclei and cytoplasm of affected osteoclasts strongly supports a viral origin (possibly related to the measles virus or respiratory syncytial virus), though definitive proof is pending. It exhibits a strong geographic and genetic predilection, affecting up to 4% of individuals of Anglo-Saxon descent over the age of 55, while remaining exceedingly rare in Asian and African populations.
Pathophysiology and Imaging
The disease process is characterized by three distinct phases:
1. Initial Osteolytic Phase: Driven by massive, multinucleated osteoclasts causing aggressive bone resorption.
2. Mixed Phase: A chaotic interplay of osteoclastic resorption and rapid, disorganized osteoblastic bone formation.
3. Osteosclerotic Phase: Dominated by dense, structurally inferior woven bone formation.
Radiographic findings correlate directly with the disease stage. In the lytic phase, advancing osteolysis in long bones creates a classic "blade of grass" or "flame-shaped" leading edge extending from the subchondral bone toward the diaphysis. In later stages, radiographs reveal profound bony sclerosis, dramatically thickened cortices, and coarsened trabeculae, often accompanied by bowing deformities.


Fig. 20-21: Paget disease of the left proximal femur in a 45-year-old man. (A) Anteroposterior radiograph shows markedly coarsened trabeculae and cortical thickening. (B) Bone scan demonstrates intensely increased radiotracer uptake in the affected proximal femur.
Bone scintigraphy (Technetium-99m) is exquisitely sensitive, showing intensely "hot" lesions. Occasionally, the combination of aggressive plain radiographic features and a positive bone scan may mimic a primary bone sarcoma. In these instances, MRI is an invaluable diagnostic tool; despite the chaotic remodeling, the marrow signal in uncomplicated Paget disease typically remains normal (isointense to fat).
Medical and Surgical Management
Histologically, the hallmark of Paget disease is the "mosaic" or "jigsaw puzzle" pattern of lamellar bone, characterized by irregular, haphazard cement lines and highly vascularized fibrous connective tissue replacing normal marrow.
Medical management is the first line of defense, utilizing bisphosphonates (e.g., zoledronic acid, alendronate) or calcitonin to suppress osteoclastic activity, alongside NSAIDs for pain control. Disease activity is monitored via serum alkaline phosphatase (ALP) and urine N-telopeptide or pyridinoline cross-links.
Orthopedic surgical intervention is indicated for:
* Deformity Correction: Corrective osteotomies for severe bowing (e.g., anterolateral bowing of the femur or tibia) that alters joint biomechanics.
* Fracture Management: Pathological fractures in Pagetoid bone are notoriously difficult to treat. The bone is simultaneously brittle ("chalk stick" fractures) and hypervascular.
Surgical Pitfall: During periods of active disease, intraoperative bleeding from Pagetoid bone can be massive. Preoperative administration of intravenous bisphosphonates for several weeks prior to elective surgery (such as joint arthroplasty or osteotomy) is highly recommended to reduce disease activity and vascularity. Furthermore, the sclerotic bone can easily dull or break standard drill bits; always have fresh, high-speed carbide drills available.
Malignant Degeneration
Approximately 1% of patients with Paget disease will develop a secondary bone sarcoma, most commonly a highly aggressive osteosarcoma. The risk is significantly elevated in patients with widespread polyostotic disease. Any new onset of severe, unrelenting pain or a rapidly expanding soft-tissue mass in a known Pagetoid lesion mandates immediate biopsy.
"Brown Tumor" of Hyperparathyroidism
Hyperparathyroidism results in excessive secretion of parathyroid hormone (PTH), leading to profound alterations in calcium and phosphate homeostasis. Primary hyperparathyroidism is most frequently caused by a solitary parathyroid adenoma. Secondary hyperparathyroidism is a compensatory response commonly seen in patients with chronic renal failure (renal osteodystrophy).
Pathophysiology and Histology
Early skeletal manifestations are typically limited to diffuse osteopenia and subperiosteal bone resorption (classically seen on the radial aspect of the middle phalanges). However, in advanced or neglected cases, the localized accumulation of osteoclasts and fibrous tissue produces a focal, expansile, lytic lesion known as a "brown tumor" (osteitis fibrosa cystica). The brown color is derived from extensive hemorrhage and hemosiderin deposition.
Histologically, a brown tumor is nearly indistinguishable from a true Giant Cell Tumor (GCT) of bone. However, subtle microscopic features favor hyperparathyroidism:
1. The multinucleated giant cells are generally smaller and tend to cluster in a nodular arrangement, particularly around areas of hemorrhage.
2. The background stromal cells are more delicate and spindle-shaped.
3. Prominent evidence of osseous metaplasia within the stroma is frequently observed.
4. The surrounding host bone exhibits intense, chaotic osteoclastic and osteoblastic activity associated with peritrabecular fibrosis.
Diagnosis and Management
The diagnosis must be established biochemically, not purely histologically. A suspected GCT should always prompt a laboratory workup including serum calcium, phosphorus, alkaline phosphatase, and intact parathyroid hormone (PTH) levels.


Fig. 20-22: (A and B) Pathological fracture of the right proximal tibia occurring through a large, expansile “brown tumor” of hyperparathyroidism in a 55-year-old woman.
Primary treatment is medical or surgical management of the underlying endocrinopathy (e.g., parathyroidectomy) by an endocrinologist or general surgeon. Following normalization of PTH levels, brown tumors typically remineralize and regress spontaneously. Orthopedic intervention is strictly limited to the stabilization of actual or impending pathological fractures. If a fracture occurs, intramedullary nailing or rigid plate osteosynthesis is required, as the structural integrity of the bone is severely compromised.
Bone Infarct (Osteonecrosis)
Bone infarcts represent areas of ischemic necrosis within the medullary cavity of the metaphysis or diaphysis. They are frequently associated with systemic risk factors, including chronic corticosteroid use, alcohol abuse, sickle cell hemoglobinopathies, Gaucher disease, and dysbaric conditions (Caisson disease). Idiopathic cases also occur.
Imaging and Diagnosis
The diagnosis is almost exclusively made via plain radiography and MRI. Radiographically, bone infarcts present as well-defined metaphyseal or diaphyseal lesions with irregular, serpiginous borders.




Fig. 20-23: (A and B) Plain radiographs demonstrating irregular, serpiginous calcification in the metaphysis of the distal femur in a 50-year-old woman with a history of chronic steroid use. (C and D) T1- and T2-weighted MRI images clearly delineate multiple medullary bone infarcts with characteristic "double-line" signs.
A critical diagnostic step is differentiating a bone infarct from an enchondroma. Bone infarcts exhibit dense, peripheral calcification with a radiolucent center, whereas chondroid lesions (enchondromas) typically display central "rings and arcs" or "popcorn" calcification throughout the lesion. Biopsy is rarely indicated but would demonstrate mineralization of necrotic marrow elements and empty osteocyte lacunae.
Management
Medullary bone infarcts are almost universally asymptomatic and require no treatment. If a patient with a radiographically confirmed bone infarct presents with localized pain, an alternative etiology must be aggressively sought. Rarely, malignant transformation—most notably into Malignant Fibrous Histiocytoma (MFH) or undifferentiated pleomorphic sarcoma—can occur at the site of a chronic bone infarct, presenting with cortical destruction and a soft-tissue mass.
Osteomyelitis Mimicking Neoplasia
Osteomyelitis, particularly in its subacute or chronic stages (e.g., Brodie's abscess), can perfectly simulate primary bone tumors. Disastrous clinical errors have occurred when attempting to differentiate atypical infections from Ewing sarcoma, osteosarcoma, osteoid osteoma